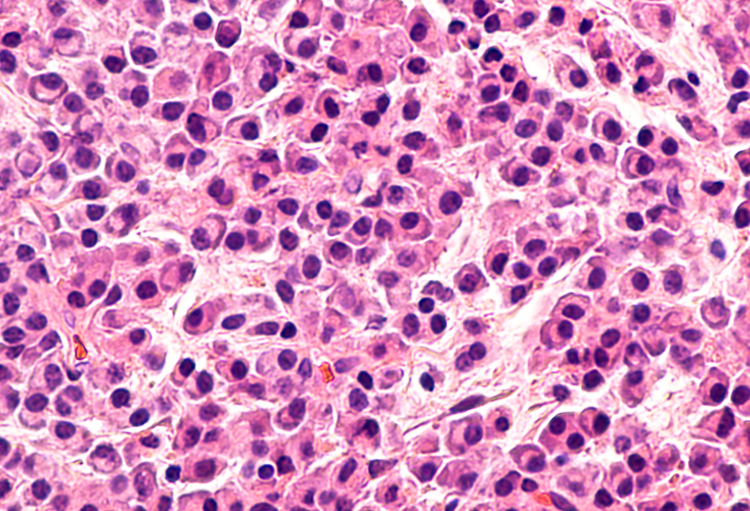
25th EHA Annual Congress:

«Pour la petite histoire, Ikema, ou plus exactement Ikema-Jima, fait partie des îles Miyako, en mer de Chine orientale, îles qui font partie de l’archipel Sakishima, lui-même inclus dans l’archipel Ryūkyū et qui dépend administrativement de la préfecture d’Okinawa, au Japon»,...
Vous souhaitez continuer à lire cet article ?
L'accès à la totalité de l'article est réservé aux professionnels de la santé.
Si vous êtes un professionnel de la santé vous devez vous connecter ou vous inscrire gratuitement sur notre site pour accéder à la totalité de notre contenu.
Si vous êtes journaliste ou si vous souhaitez nous informer écrivez-nous à redaction@rmnet.be.